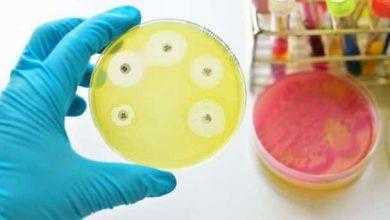
الامم المتحدة تجتمع لمناقشة الميكروبات المقاومة للمضادات الحيوية

الغذاء والدواء الأمريكية توافق على استخدام جرعة داعمة من فايزر للأطفال
منحة إدارة الغذاء والدواء الأمريكية الموافقة على استخدام جرعة داعمة من فايزر للأطفال من عمر 5 إلى 11 عامًا، على أن يتلقى الأطفال جرعة واحدة معززة بعد مرور 5 أشهر على الأقل من تلقي الجرعات الأساسية من اللقاح.
جرعة داعمة من فايزر للأطفال
أعلن الدكتور روبرت كاليف، مفوّض إدارة الغذاء والدواء، موافقة الإدارة على الاستخدام الطارئ لجرعة داعمة من لقاح فايزر للأطفال، من عمر 5 إلى 11 عام، ولكن بشرط مرور 5 أشهر على تلقي الطفل التطعيم الأساسي ضد فيروس كورونا.
وصرح الدكتور روبرت، أنه على الرغم من أن أعداد الإصابة بفيروس كورونا (في بداية انتشار الفيروس) بين الأطفال أقل بكثير من الكبار، والأعراض الظاهرة عليهم أقل حدة، شهد العالم في الفترة الأخير تزايد كبير في عدد الإصابات بين الأطفال؛ نتيجة لانتشار متحور أوميكرون.
وأضاف الدكتور روبرت، أن تلقي اللقاح ضد فيروس كورونا لا يزال أفضل طريقة للوقاية من الإصابة بالفيروس، وتجنب حدوث أي مضاعفات خطيرة.
اقرأ أيضًا:
تقييم سلامة الجرعة الداعمة من اللقاح
يُذكر أن لقاح فايزر قد حصل على الموافقة للاستخدام في الأطفال في العام الماضي (2021)، وحصل على الموافقة على استخدام جرعة معززة في البالغين في شهر يناير الماضي.
وقد أوضحت البيانات أن فاعلية اللقاح تقل بمرور الوقت بعد تلقي الجرعة الثانية؛ ما دفع إدارة الغذاء والدواء للموافقة على منح جرعة معززة للبالغين.
وقد منحت الإدارة تصريح الاستخدام الطارئ لـ جرعة داعمة من فايزر للأطفال بعد تقييم سلامة تلقي جرعة واحدة معززة من اللقاح فيما يقارب 400 طفل، من عمر 5 إلى 11 عام، بعد 5 أشهر من تلقي الجرعة الأساسية من اللقاح.
واستمرت الدراس لمدة تصل إلى 9 أشهر للتأكد من سلامة الجرعة. أما عن الأعراض الجانبية للجرعة، فقد ظهر على الأطفال بعض الأعراض البسيطة، مثل:
- الصداع.
- احمرار مكان الحقن، وتورم.
- ارتفاع في درجة الحرارة.
- ألم في المفاصل.